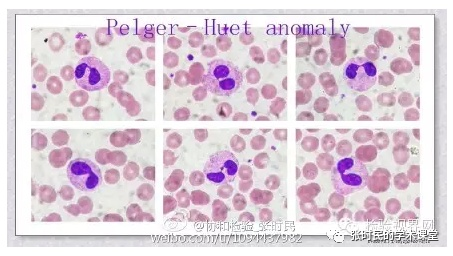

Pelger-Huët畸形与假性Pelger-Huët畸形
这是一种具有独特形态的中性粒细胞,具有眼镜一样的核型,易认易记得,但有时候会出现一些误认或模糊的概念,他就是Pelger-Huët畸形。
Pelger-Huët畸形可被译作佩尔格-休特畸形,在国内还有人把他称为派胡细胞或者译作佩-休二氏异常。在许多教科书、专著上和图谱书上对这种细胞的介绍篇幅也不是很多。因为对那个带有两个小点的字母e比较难输入电脑中,所以经常将其写为Pelger-Huet畸形(本文后面均使用这个写法),其实具有这种细胞核的疾病的名称是以两位发现该病的医生的姓氏组合而命名的,文章后面会提到。
由于其特殊的形态特点,也曾经令我颇感兴趣,于是查阅了更多的资料,特别是国外资料,并配合我自己拍摄的图谱照片,综合起来介绍给大家。
01 真性Pelger-Huet畸形
白细胞的中性粒细胞核分叶过少,
其细胞核多仅分为2叶,或杆状核形似花生样,分叶核的两分叶之间多以细丝状连接(形似眼镜);
典型的核型可呈肾形、眼镜形或哑铃形;叶多呈圆形或椭圆形;细胞质较为致密、深染,聚集成小块或条索状,其间可有空白间隙。
其形特点如图1,为一个眼镜形核的细胞,图2为两个典型的眼镜核形细胞和似花生样核的细胞杆状细胞(图2左下)。外周血涂片既可以识别出此类细胞。(插图来自张时民、王庚主编《血象-外周血细胞图谱》P85、P86页)


这种特殊形态的细胞的出现被认为是成熟中性粒细胞核分叶能力减退,或细胞成熟障碍。
一般为常染色体显性遗传性性疾病,也称家族性粒细胞异常,又名Pelger-Huet粒细胞异常症。
其特点是多数白细胞,甚至90%以上的成熟中性粒细胞不分叶或仅分两叶,
除粒细胞形态异常外,其吞噬等功能正常,一般无临床症状,
常规血涂片检查或其他疾病检查血象时方始发现,血细胞分析仪一般不会出现报警信息或核左移的报警提示。
这种常染色体显性遗传疾病主要为杂合子型,这种仅分为杆状核或仅分2叶核的细胞有可能会被误认作是未成熟细胞,从而导致误诊。
具有这种形态特点的白细胞在1928年由荷兰血液病医生Pelger首次报道,并于1931年由儿科医生Huet确认它是一种遗传性疾病,故这个细胞的名称就是他二人的姓氏组合而成。
纯合子型其细胞分叶往往为圆形的核叶,并可能有功能性问题。纯合子型个体的临床表现不一,可出现骨骼畸形,如多指症、短掌骨、短上肢,身材矮小或脊柱后凸。
据1984年国内文献报道,某学校于1983年3月发现一女学生外周血中出现粒细胞核不分叶现象,经对该学生家系调查,在本家系成员24人中发现14例中性粒细胞出现Pelger-Huet畸形的个体。其他遗传性家族病的病例报道还有很多。
02 假性Pelger-Huet畸形
如果继发于严重感染的核分叶能力减退,则被称为获得性或假性Pelger-Huet畸形(Acquired or pseudo-Pelger–Huet anomaly)。
其核的形状特征类似Pelger–Huet异常,但核染色质浓缩程度明显低于真性Pelger-Huet畸形。
其数量在中性粒细胞中>4%。
在骨髓增生异常综合征(MDS)、急性髓细胞性白血病也可见,还偶见于原发性骨髓纤维化、慢性粒细胞白血病。


图3和图4为一感染性疾病患者外周血,其中性粒细胞数量众多,但可见少许眼镜核型的中性粒细胞,其细胞分叶之间以丝状连接,形态类似Pelger-Huet畸形,但染色质较为疏松,数量较少,根据病情诊断,为假性Pelger-Huet畸形。在外周血涂片中发现假性Pelger-Huet畸形时,除了在MDS、CML时出现,往往还出现在一些疾病晚期患者,如
大剂量化疗病人 粘液性水肿 垂体功能减退 维生素B12和叶酸缺乏 多发性骨髓瘤 肠道病毒感染 疟疾 肌营养不良 类白血病反应转移到骨髓 早期骨髓发育不良 药物过敏(如磺胺类和丙戊酸盐类药物毒性)
在这些疾病中,尤其是药物诱导的情况下,识别出这种获得性或假性Pelger-Huet异常是非常重要的,因为它省却了需要进一步进行癌症排除的不必要的检测需求。
下面图5和图6是作者以前在新浪微博中发布的Pelger-Huet畸形图片。

◂ 左右滑动查看 ▸
03 小结
根据已发表的一些文献报道,作者认为识别出Pelger-Huet畸形及假性Pelger-Huet畸形都是有意义的,应该及时与临床沟通。他们都是有意义的发现,尽管某些是家族性遗传患者,可能没有任何临床症状,也是有价值的发现,可用于诊断和治疗。
典型的核型可呈肾形、眼镜形或哑铃形;叶多呈圆形或椭圆形;细胞质较为致密、深染,聚集成小块或条索状,其间可有空白间隙。
区别如下表。
Pelger-Huet畸形 | |
先天性 | 假性或称获得性 |
核分叶两叶 多呈圆形或椭圆形 | 核分叶 多分为两叶 |
核染色质 致密、深染, 聚集成小块或条索状 其间可有空白间隙 | 核染色质 浓缩不明显, 形成条索状 |
一般无临床症状 | 常见于MDS AML CML 可继发于某些严重感染 偶见于IMF 肿瘤转移 或某些药物治疗后 |
Pelger-Huët异常是
一种公认的中性粒细胞的形态学异常,在多形核中性粒细胞中最为明显。
是一种易于发现的遗传性疾病导致的形态学改变,
检验人发现后一定要引起注意。

